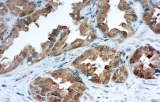
Galectina-3

La inmunohistoquímica (IHQ) se ha convertido en un componente esencial de la patología tiroidea y paratiroidea moderna, sirviendo como complemento clave a la evaluación histomorfológica. Su uso es particularmente relevante en biopsias pequeñas, estudios de metástasis y casos con características arquitecturales superpuestas o limitadas. Las neoplasias tiroideas y paratiroideas representan una proporción significativa de tumores endocrinos encontrados en la práctica rutinaria de patología quirúrgica en esta región anatómica.
La aplicación de anticuerpos primarios validados CE/IVD proporciona un marco regulado para la detección de proteínas asociadas a linaje y diferenciación en tejido fijado en formalina e incluido en parafina (FFPE). Cuando se implementan en flujos de trabajo validados por el laboratorio e interpretados junto con controles adecuados, estos reactivos apoyan un rendimiento analítico estandarizado e interpretación clínicamente significativa. Como con todos los reactivos IVD, la verificación específica del laboratorio y la interpretación contextual siguen siendo esenciales.
Marcadores inmunohistoquímicos clave en patología tiroidea y paratiroidea
Linaje y diferenciación tiroidea
Tiroglobulina (Tg)
La tiroglobulina se utiliza ampliamente como marcador de epitelio folicular tiroideo diferenciado y es útil para respaldar el origen tiroideo tanto en lesiones primarias como metastásicas. La expresión puede estar reducida, focal o ausente en carcinomas tiroideos poco diferenciados o desdiferenciados; la interpretación debe considerar posibles limitaciones técnicas y contextuales.
PAX8
PAX8 es un factor de transcripción nuclear expresado en células foliculares tiroideas y es útil para respaldar el linaje tiroideo, particularmente en tumores con expresión disminuida o ausente de tiroglobulina. La interpretación requiere conciencia de que la expresión de PAX8 no es específica del tejido tiroideo y puede observarse en neoplasias epiteliales no tiroideas seleccionadas.
Carcinoma medular de tiroides
Calcitonina
La calcitonina es el marcador inmunohistoquímico principal de diferenciación de células C parafoliculares y es central para el diagnóstico de carcinoma medular de tiroides en la mayoría de los casos. Aunque muestra alta utilidad diagnóstica en entornos primarios y metastásicos típicos, se han reportado tumores calcitonina-negativos raros; los resultados deben interpretarse junto con morfología, hallazgos clínicos y estudios complementarios cuando esté indicado.
Lesiones tiroideas derivadas de folículos: benignas y malignas
Galectina-3
La galectina-3 es uno de los marcadores inmunohistoquímicos más estudiados en patología tiroidea y se expresa con mayor frecuencia en tumores malignos derivados de folículos que en nódulos benignos. Sin embargo, también puede observarse expresión en ciertas condiciones tiroideas benignas o inflamatorias. Por lo tanto, su valor diagnóstico es mayor cuando se utiliza como parte de un panel inmunohistoquímico multiparamétrico en lugar de como marcador independiente.
Diferenciación paratiroidea
Hormona paratiroidea (PTH)
La hormona paratiroidea es un marcador clave para confirmar el origen paratiroideo y es particularmente útil en el diagnóstico diferencial entre lesiones paratiroideas y tiroideas con características histológicas superpuestas. Apoya la confirmación de linaje en adenomas paratiroideos, carcinomas y tejido paratiroideo ectópico o intratiroideo; la interpretación se realiza en correlación con morfología y hallazgos clínicos.
Consideraciones para anticuerpos primarios marcados CE / validados IVD
- Destinados al uso diagnóstico clínico bajo el Reglamento Europeo de Diagnósticos In Vitro (IVDR 2017/746).
- Apoyan rendimiento analítico estandarizado para confirmación de linaje y clasificación tumoral en patología tiroidea y paratiroidea.
- Facilitan enfoques diagnósticos basados en paneles consistentes con literatura patológica publicada y recomendaciones de práctica.
- Requieren verificación específica del laboratorio, controles adecuados e interpretación en el contexto clinicopatológico completo, independientemente del estado regulatorio.